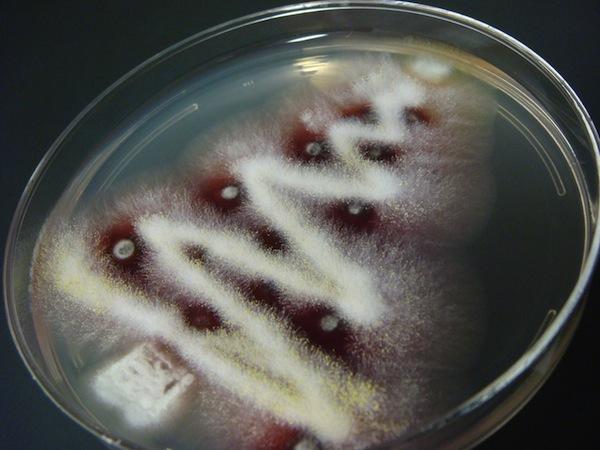

小時候常看到一個習慣不太好的強者我同學把沒吃完的土司麵包隨手就丟進抽屜或書包裡,當下次重逢時,被壓到稀巴爛只是最基本的,噁心一點的就會長出青一塊紫一塊的黴菌,讓人看了忍不住直呼好胎哥!這時同學表示:你們都太膚淺了,這是種藝術創作啊~(被毆)

多年後的今天發現我們都錯怪了這位同學,原來黴菌是真的可以拿來做藝術創作啊!美國J. Craig Venter生物科學研究所裡的Stephanie Mounaud在工作之餘,創作出這一系列慶賀聖誕節的可愛圖案。培養皿中這些聖誕樹千真萬確是由平常被大家視為噁心象徵的黴菌所打造,鮮豔繽紛的色彩,搭配上毛茸茸的感覺,瞬間讓大家對黴菌改觀!

這頂聖誕帽是Mounaud今年最新的創作,別看這些圖案相當簡單,其實想控制黴菌的生成有相當的難度,需要經過長時間的規劃與嘗試才能成功。而且這樣的好東西千萬別拿出來輕易獻寶,當然不是擔心會有人把它搶走,而是因為無所不在的黴菌很容易就透過空氣散佈至生活周遭,到時名牌包包或皮衣上就有片片雪花得整理了~
下次看到家中小朋友把吃不完的麵包塞進抽屜裡,別再罵他們不衛生了,或許應該多買幾塊讓他們塞才能刺激創作靈感呢(大誤)。
延伸閱讀
美麗的包裝裡藏什麼?X光下的聖誕禮物
聖誕老人的祕密基地-勤美天地聖誕村
【DIY OK】聖誕佳節自己做樂高聖誕樹卡片最有誠意~
令人毛骨悚然的細菌廣告看板!Contagion
----
「大人物噗浪」跟「大人物臉書」跟「大人物G+」你....還沒加嗎?
若想分享創意或新聞訊息,歡迎寄至[email protected]
來源網站/source、source2
